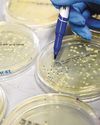

Poging GOUD - Vrij
The Straits Times - October 14, 2025

Ga onbeperkt met Magzter GOLD
Lezen The Straits Times samen met 9000+ andere tijdschriften en kranten met slechts één abonnement
Bekijk catalogusAbonneer u alleen op The Straits Times
Op elk gewenst moment opzegbaar.
(Geen verplichtingen) ⓘAls u niet tevreden bent met uw abonnement, kunt u binnen 7 dagen na de ingangsdatum van het abonnement een e-mail sturen naar help@magzter.com voor een volledige terugbetaling. Geen vragen gesteld - beloofd! (Let op: niet van toepassing op losse nummers)
Digitaal abonnement
Directe toegang ⓘAbonneer je nu en begin direct met lezen via de Magzter website, iOS, Android en Amazon apps.
Geverifieerd beveiligd
betaling ⓘMagzter is een geverifieerde Stripe-handelaar.
In dit nummer
October 14, 2025
The Straits Times Description:
Unlock your access to award-winning journalism on Singapore and the world. With bureaus in major cities around the world, The Straits Times correspondents bring world news to readers on a Singapore platter, helping them appreciate world events from a Singaporean perspective.
Recente nummers

October 13, 2025

October 12, 2025

October 11, 2025

October 10, 2025

October 09, 2025

October 08, 2025

October 07, 2025

October 06, 2025

October 05, 2025

October 04, 2025

October 03, 2025

October 02, 2025

October 01, 2025

September 30, 2025

September 29, 2025

September 28, 2025

September 27, 2025

September 26, 2025

September 25, 2025

September 24, 2025

September 23, 2025

September 22, 2025

September 21, 2025

September 20, 2025

September 19, 2025

September 18, 2025

September 17, 2025

September 16, 2025

September 15, 2025
Gerelateerde titels

Business Standard

Hindustan Times

Mint Mumbai

The Morning Standard

The Free Press Journal

Financial Express Delhi

The New Indian Express

The Statesman

Millennium Post Delhi

Hindustan Times Mumbai

The Business Guardian

Hindustan Times Bengaluru

Hindustan Times Pune

Hindustan Times Chandigarh

Hindustan Times Gurugram

Hindustan Times Lucknow

Hindustan Times Patna

Hindustan Times Noida

Hindustan Times Jaipur

Hindustan Times Ranchi

Hindustan Times East UP

Hindustan Times Navi Mumbai

Hindustan Times Ludhiana

Hindustan Times Uttarakhand

Hindustan Times West UP

Hindustan Times Punjab

Hindustan Times Rajasthan

Hindustan Times Amritsar

Hindustan Times Haryana

Hindustan Times Thane